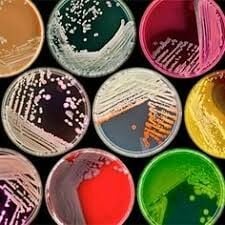

Petri Kabı Rehberi: Cam, Plastik, Paslanmaz Çelik ve PTFE Kaplarıyla Tanışın
Bugün hiçbir biyolog veya kimyager onlarsız yapamaz: Petri kapları, bakteri ve mantar yetiştirme gibi mikroorganizmaların yetiştirilmesinden hücre kültürlerinin incelenmesine kadar çok çeşitli uygulamalar için laboratuvar araştırmalarında kullanılan temel araçlardır.
Düz, yuvarlak ve şeffaftır ve sayısız bilimsel keşfi mümkün kılmıştır: Julius Richard Petri bunu icat ettiğinde 25 yaşındaydı ve Berlin'de ünlü mikrobiyolog Robert Koch'un asistanı olarak çalışıyordu.
1877'de genç araştırmacı, bakteri yetiştirmek için bir cam şişenin tabanını kullanma fikrini ortaya attı. Bunun için, kültür ortamı olarak alglerden elde edilen bir jelleştirici madde kullandı. Bu "agar plakası" ilk kez Petri tarafından kabın içinde tutuldu ve böylece büyüyen mikroorganizmalara su ve besin sağlayabildi.
Petri kabının tıp üzerindeki etkisi olağanüstüdür. Alexander Fleming'in bir Petri kabında tesadüfen penisilini keşfetmesini ele alalım. Bu olay, antibiyotik çağını başlattı ve bulaşıcı hastalıkların manzarasını sonsuza dek değiştirdi ve tıp uygulamasının kendisini devrim niteliğinde değiştirdi.
Petri kapları cam, plastik, ptfe ve paslanmaz çelikten çeşitli boyutlarda üretilir. Doğru kabı seçerek petri kaplarınızın uzun ömürlü ve etkili olmasını sağlayabilir, daha doğru ve güvenilir bilimsel sonuçlara ulaşabilirsiniz. Laboratuvar araştırma ihtiyaçlarınız için Borox'un petri kaplarının kalitesine güvenin.
Cam Petri Kabı: Cam petri kapları, laboratuvarlarda en yaygın kullanılan türlerden biridir. Yüksek sıcaklık dayanımı ve kimyasal dirençleri sayesinde, sterilizasyon işlemlerinde tercih edilirler. Genellikle şeffaf olup, içindeki kültürlerin gözlemlenmesi kolaydır.
Plastik Petri Kabı: Plastik petri kapları, genellikle polistiren veya polipropilen gibi malzemelerden yapılır. Hafif olmaları, dayanıklı ve kırılmaya karşı dirençli olmalarını sağlar. Cam petri kaplarına göre daha uygun fiyatlıdır ve tek kullanımlık olarak kullanıldığında sterilizasyon işlemleri gerektirmez.
Paslanmaz Çelik Petri Kabı: Paslanmaz çelik petri kapları, kimyasal ve mekanik dayanıklılığı ile bilinir. Bu tür petri kapları, özellikle uzun süreli kullanım ve yüksek sıcaklık gerektiren uygulamalarda tercih edilir. Kolayca temizlenebilir ve sterilize edilebilirler.
PTFE Petri Kabı: PTFE (politetrafloroetilen) petri kapları, yüksek kimyasal dirençleri ile dikkat çeker. Özellikle agresif kimyasallar ve yüksek sıcaklıklar altında stabil kalırlar. Ayrıca, PTFE kaplaması sayesinde, yapışkan maddelerle çalışırken temizlik işlemleri oldukça kolaydır.
Petri Kabı Standı: laboratuvarlarda düzeni sağlamaya ve petri kaplarını güvenli bir şekilde saklamaya yardımcı olur. Cam, plastik, paslanmaz çelik ve PTFE petri kapları için uygun seçenekler sunar. Standlar, kapların düzenli bir şekilde saklanmasını ve kolay erişimini sağlar, ayrıca kapların sterillik ve temizlik durumunu korumaya yardımcı olur. Dayanıklı ve pratik tasarımları sayesinde laboratuvar çalışmalarında büyük kolaylık sağlar.


Daha fazla bilgi ve ürün seçenekleri için Blab Market sayfamızı ziyaret edebilirsiniz.



